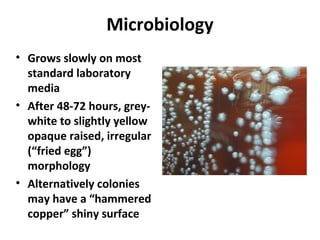
Microbiology
• Grows slowly on most
standard laboratory
media
• After 48-72 hours, grey-
white to slightly yellow
opaque raised, irregular
(“fried egg”)
morphology
• Alternatively colonies
may have a “hammered
copper” shiny surface

The document provides a comprehensive overview of the plague caused by Yersinia pestis, detailing its history, microbiology, epidemiology, and treatment. It highlights major pandemics, including the Justinian Plague and the Black Death, as well as modern occurrences of the disease, emphasizing the importance of flea vectors and animal reservoirs. Diagnostic methods and treatment options, including antibiotic use and prophylaxis for at-risk individuals, are also discussed.